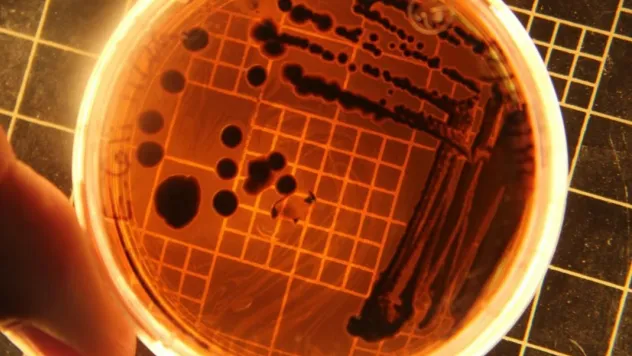
Yaz sıcağında süt ve süt ürünlerine dikkat: Uzmanlardan gıda zehirlenmesi uyarısı

Gündem
Kayseri gündemi

Uyuşturucuyla mücadelede annelere bilinçlendirme semineri

Külliyeden medreseye: Kayseri’de Selçuklu mirası

Komutan Dedebağı için veda yemeği düzenlendi

24 Ağustos ve 30 Ağustos Günü Cumhuriyet Meydanı trafiğe kapatılacak

Erciyes'in eteklerinde tarih ve doğanın buluştuğu ilçe : Develi

Yüzde 60 iş gücü kaybı olanlara erken emeklilik hakkı

Kayseri’de bir 14.yy yapısı: Emir Sultan Mescit ve Türbesi

Erciyes’te Heyecan Dolu Voleybol Turnuvası

Saadet Partisi'nden Tomarza'da halk buluşması

KAYMEK'ten Yaz Dönemi Kapanış Programı

Kayseri’de yapılacak planlı elektrik kesintileri (22 Ağustos)

Kayseri hafta sonu ‘Sıcak’ geçecek

AK Parti Kayseri İl Yönetiminden 7 kişinin istifası istendi

Yataş işçisi Kozan; “Sendikayla görüşmemizi istemedikleri için bizi dışarıya çıkarmadılar"

Yataş’ta işten çıkarılan işçiler şikayette bulundu

Evliya Çelebi, Kayseri’de 74 yeri gezdi

30 noktada telsiz bağlantıları kurularak haberleşme tatbikatı düzenlendi

Develi’de iş makinesine çarparak yaşamını yitiren motosiklet sürücüsü toprağa verildi
Yaz sıcağında süt ve süt ürünlerine dikkat: Uzmanlardan gıda zehirlenmesi uyarısı

İslami Tatilin Güvencesi: Şah Inn Paradise Tatil Köyü

Yüksek sesle müzik dinleyen 562 sürücüye ceza işlem

Milletvekili Cıngı, Sivas ve Ulaş'ta Vatandaşlarla Buluştu

Kayseri'de Dilencilikle Mücadele Denetimleri

Başkan Büyükkılıç: 'Teşekkürler Kayseri'

Melikgazi'de Ali Erkara Cami Açılıyor

Türkiye’den, İsrail’e deniz ticaretine tam yasak

Kocasinan'da Görülmeye Değer Yerler

Mevsim meyveleri el yakıyor: Pazar tezgahlarının en ucuzu domates

Sağlıklı Yaşam ve Farkındalık Kampı başvuruları başladı

Kayseri’de büyükbaş hayvan sayısı arttı

Uzman Yardımcısı teminine yönelik başvurular 25 Ağustos’ta sona erecek

SGK: Yetkisiz sağlık hizmetlerinin gideri ödenmeyecek

Müzik terapisi psikolojik tedavide kullanılır mı?

Kayseri Ticaret Borsası listesine göre et ve tahıl fiyatları

Çopuroğlu, “Sahada, milletimizle omuz omuzayız”

Kayserili halk ozanı: Aşık Seyrani

FETÖ/PDY üyesi hükümlü yakalandı

Mimar Sinan’ın çıraklık eseri: Şehzade Camii

Kayseri’de planlı elektrik kesintileri (21 Ağustos)

Kayseri'de Kaçan Motosiklet Sürücüsü Kepçeye Çarparak Hayatını Kaybetti















